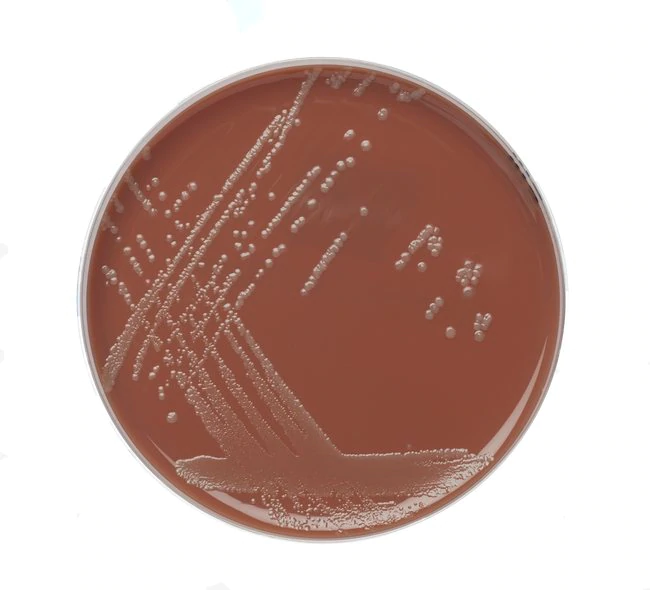
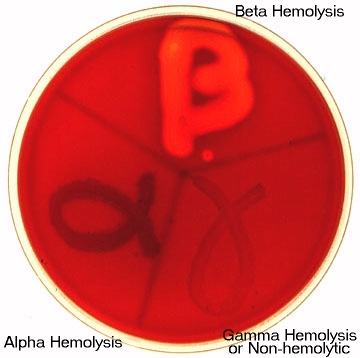
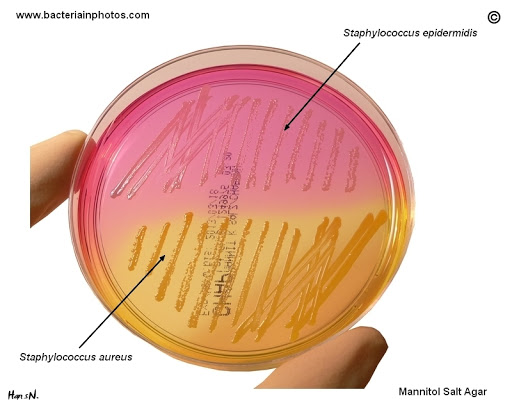
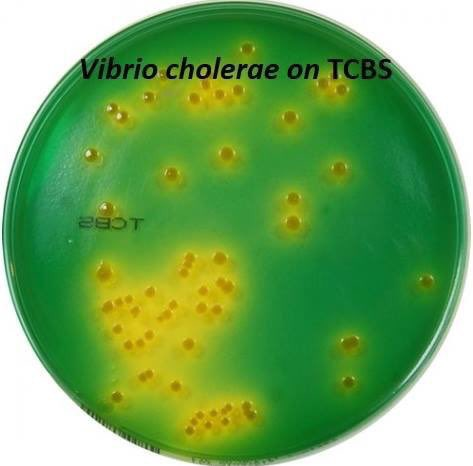
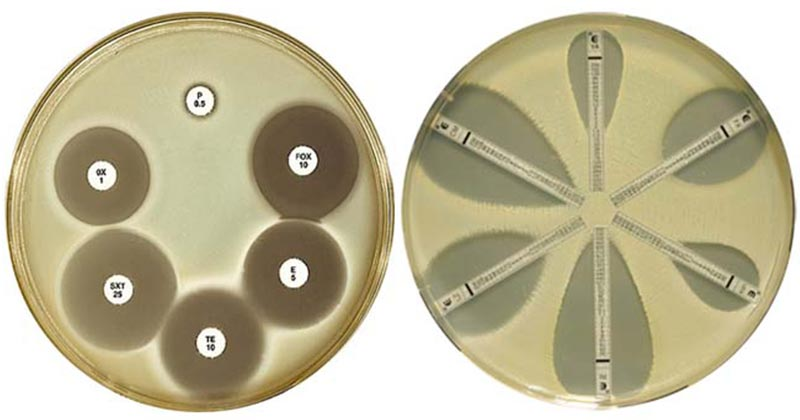
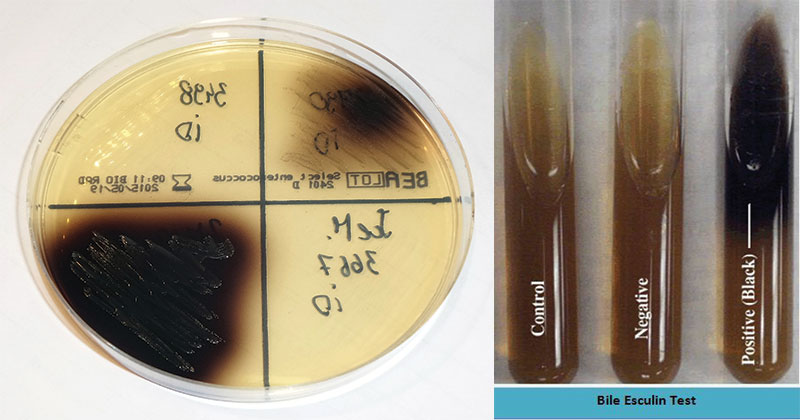

في نوعين للميديا اعتماداً على قوامها ووظيفة الميديا .
1-Based on the consistency :
- Solid media
- Semisolid media
- Liquid media
1-Based on the consistency :
- Solid media
- Semisolid media
- Liquid media
الميديا الصلبه وسبب استخدامها(solid media )
Colony morphology, pigmentation, hemolysis can be appreciated
نستخدمها لنشوف شكل المستعمرات واللون واذا البكتيريا حللت أي مواد
contains 2% agar
Colony morphology, pigmentation, hemolysis can be appreciated
نستخدمها لنشوف شكل المستعمرات واللون واذا البكتيريا حللت أي مواد
contains 2% agar
الميديا الشبه سائله وسبب استخدامها(semisolid)
For inoculum preparation, Blood culture, for the isolation of pathogens from a mixture.
Referred as “ broth
لتحضير اللقاح ، لعزل مسببات الأمراض من الخليط.
For inoculum preparation, Blood culture, for the isolation of pathogens from a mixture.
Referred as “ broth
لتحضير اللقاح ، لعزل مسببات الأمراض من الخليط.
الميديا السائله وسبب استخدامها (liquid)
useful in demonstrating bacterial motility and separating motile from non- motile strains.
السائلة مميزه لانها تفرق بين البكتيريا الحركيه
useful in demonstrating bacterial motility and separating motile from non- motile strains.
السائلة مميزه لانها تفرق بين البكتيريا الحركيه
النوع الثاني من الميديات اعتماداً على وظيفة الميديا
2-Based on the function or property:
- Simple media
- Enriched media
- Enrichment broth
- Selective media
- Indicator media
- Differential media
- Transport media
2-Based on the function or property:
- Simple media
- Enriched media
- Enrichment broth
- Selective media
- Indicator media
- Differential media
- Transport media
3-MacConkey Agar
• بيئة تفريقية للتفريق بين البكتيريا المخمرة للاكتوز Lactose fermenting والتي تأخذ اللون الأحمر مثل E.coli و Klebsiella و Enterobacter ، وبين البكتيريا الغير مخمرة للاكتوز Non-lactose fermenting والتي ليس لها لون (شفاف) مثل Proteus و Salmonella و Shigella .
• بيئة تفريقية للتفريق بين البكتيريا المخمرة للاكتوز Lactose fermenting والتي تأخذ اللون الأحمر مثل E.coli و Klebsiella و Enterobacter ، وبين البكتيريا الغير مخمرة للاكتوز Non-lactose fermenting والتي ليس لها لون (شفاف) مثل Proteus و Salmonella و Shigella .
4- Stine Lactose electrolyte deficient (CLED)
• وسط لزراعة عينات الجهاز البولي .
• بيئة تفريقية للتفريق بين البكتيريا المخمرة للاكتوز Lactose fermenting والتي تأخذ اللون الأصفر مثل E.coli ، وبين البكتيريا الغير مخمرة للاكتوز Non-lactose fermenting
• وسط لزراعة عينات الجهاز البولي .
• بيئة تفريقية للتفريق بين البكتيريا المخمرة للاكتوز Lactose fermenting والتي تأخذ اللون الأصفر مثل E.coli ، وبين البكتيريا الغير مخمرة للاكتوز Non-lactose fermenting
6- Salmonella Agar (S.S Agar) Shigella
• بيئة اختيارية لا تسمح بنمو البكتيريا الموجبة لصبغة جرام وبعض البكتيريا السالبة لصبغة جرام ماعدا Salmonella Shigella & بسبب وجود Na-citrate & bile salts
• بيئة تفريقية لـ Salmonella و Shigella حيث أن الـ Salmonella تأخذ لون البيئة (شفاف)
• بيئة اختيارية لا تسمح بنمو البكتيريا الموجبة لصبغة جرام وبعض البكتيريا السالبة لصبغة جرام ماعدا Salmonella Shigella & بسبب وجود Na-citrate & bile salts
• بيئة تفريقية لـ Salmonella و Shigella حيث أن الـ Salmonella تأخذ لون البيئة (شفاف)
مع وجود لون أسود في المركز نتيجة تحلل مواد موجودة في البيئة ينتج عنها غاز H2S والـ Shigella تأخذ مستعمراتها لون الوسط(شفاف) .
10- Bile Esculine
• بيئة تفريقية بين الأنواع المختلفة من الـ Streptococcus و الـ Enterococcus (Strept. Faecalis) التي تفرز عند نموها على هذه البيئة إنزيماً يفكك مادة الأسكولين فيتشكل مركب أسكولتين والذي يتحد مع أيونات الحديد الموجود بالبيئة على شكل سترات الحديد
• بيئة تفريقية بين الأنواع المختلفة من الـ Streptococcus و الـ Enterococcus (Strept. Faecalis) التي تفرز عند نموها على هذه البيئة إنزيماً يفكك مادة الأسكولين فيتشكل مركب أسكولتين والذي يتحد مع أيونات الحديد الموجود بالبيئة على شكل سترات الحديد
بالنسبة لتحضير الميديا بالاب فهو جداً سهل
بس اتبع تعليمات الكيت والورقه الخاصة بالشركه المصنعة وانتبه تخلط الأوراق لأن كميات المواد وطريقة تحضريها تختلف من شركه الى شركة
بس اتبع تعليمات الكيت والورقه الخاصة بالشركه المصنعة وانتبه تخلط الأوراق لأن كميات المواد وطريقة تحضريها تختلف من شركه الى شركة
وبالتوفيق للجميع بالمختبر
Always believe in yourself💪💪
Always believe in yourself💪💪
جاري تحميل الاقتراحات...